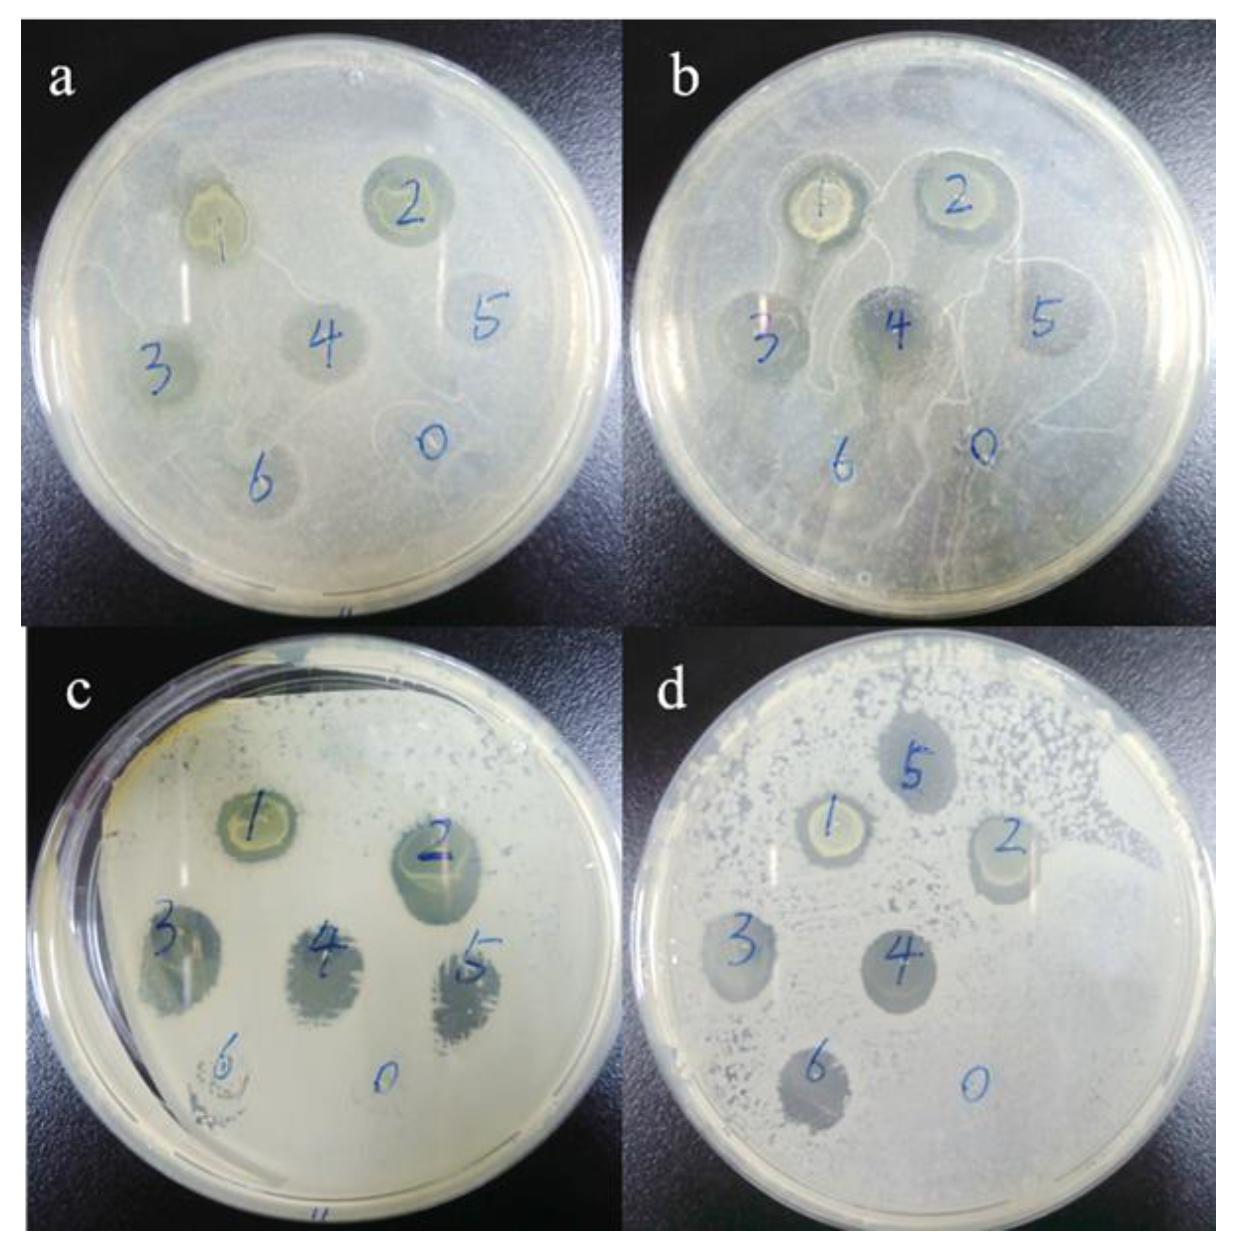
Materials 12 03980 g012 Materials 12 03980 g012
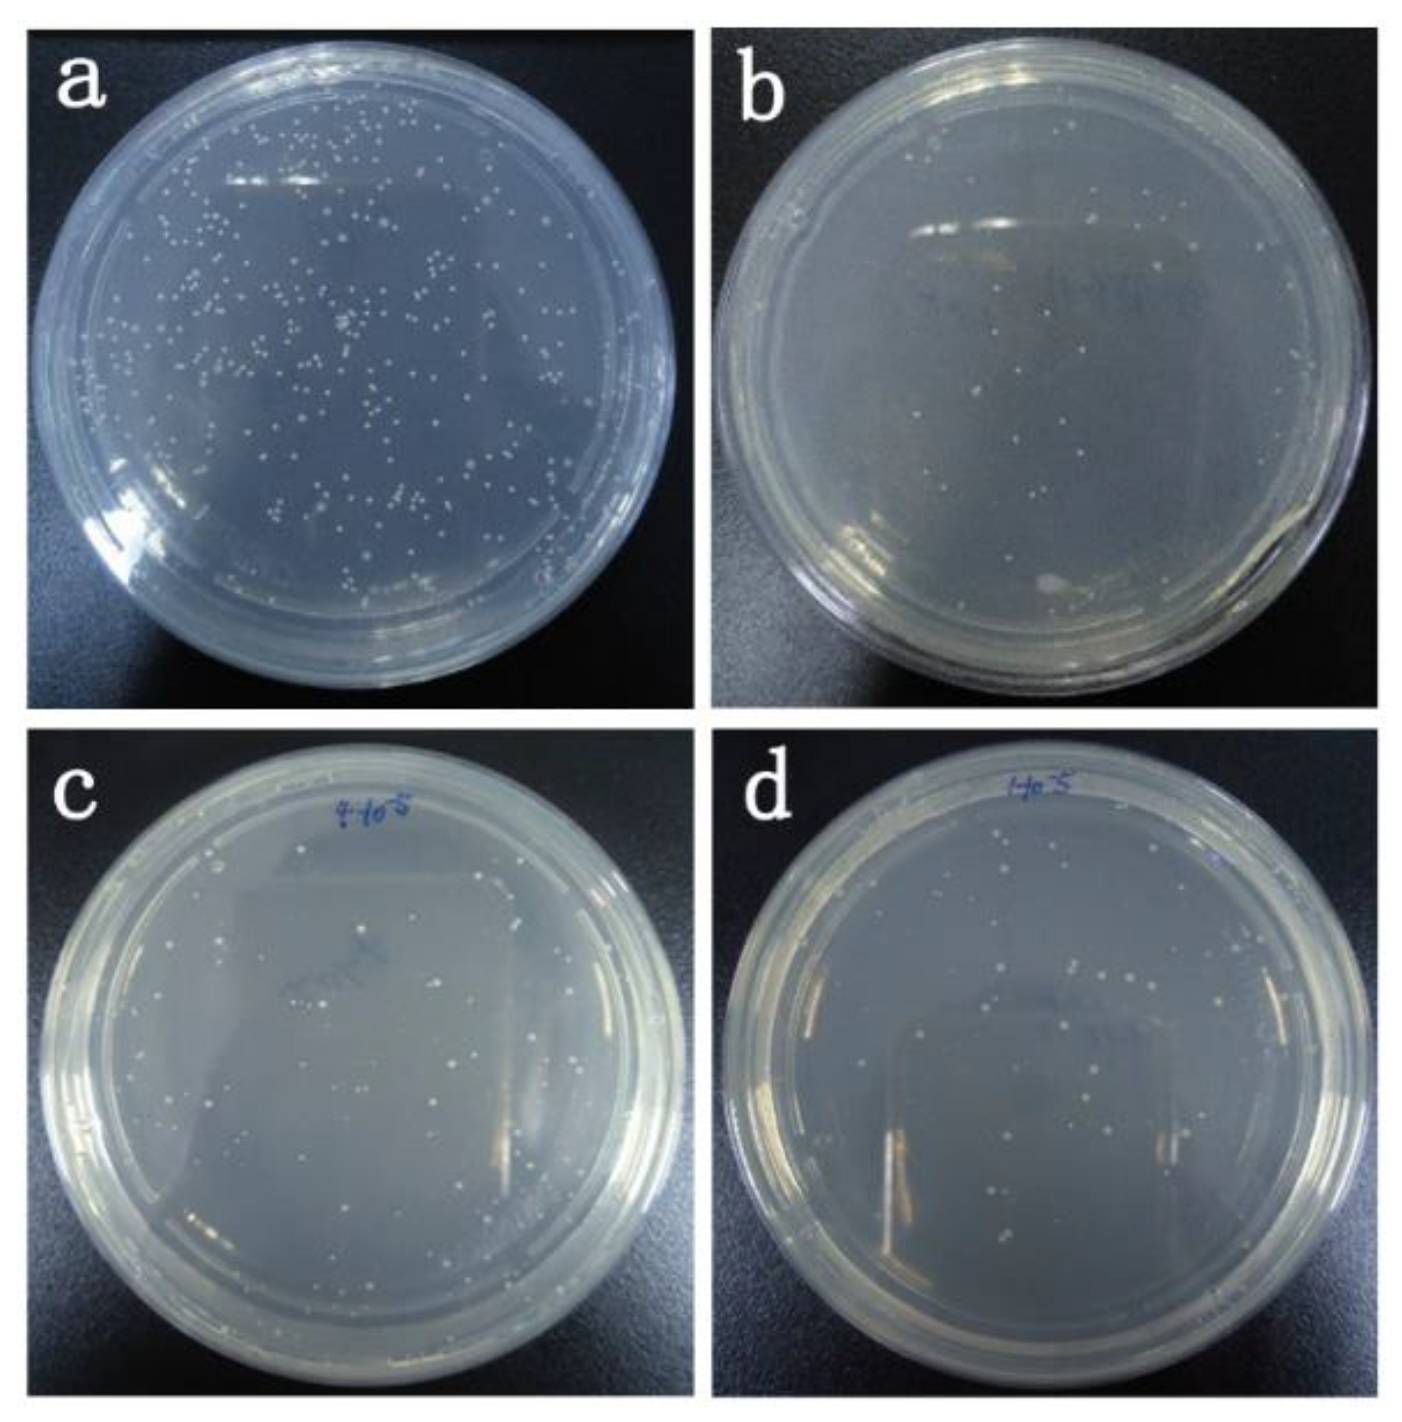
Materials 12 03980 g013 Materials 12 03980 g013

Modification of Polyacrylonitrile Fibers by Coupling to Thiosemicarbazones
Abstract
1. Introduction
2. Materials and Methods
2.1. Materials
2.2. Synthesis Methods of Thiosemicarbazone Compounds
2.3. 1HNMR (600 MHz) Spectra of the as Synthesized Thiosemicarbazone Compounds in Dimethyl Sulfoxide (DMSO) Presenting the Signals as Follows: (Chemical Shift in ppm, Varian Mercury 600 spectrometer)
2.4. Graft Modification
2.5. Grafting Efficiency Calculation
2.6. Scanning Electron Microscope (SEM) Analysis
2.7. FTIR Analysisg5g5
2.8. Tyrosinase Activity Analysis
2.9. Electron Paramagnetic Resonance (EPR) Measurements
2.10. Tensile Fracture Strength Analysis
2.11. Determination of the Stability Constant of the Obtained Complexes
2.12. X-ray Photoelectron Spectroscopy (XPS)
2.13. The Cytotoxic Effect by 3-(4,5-Dimethylthiazol-2-yl)-2,5-diphenyltetrazolium bromide (MTT) Assays
2.14. Antibacterial Test
3. Results
3.1. Determination of Tyrosinase Activity
3.2. Cytotoxicity Analysis
3.3. EPR Measurements
3.4. Potentiometric Titration
3.5. X-ray Photoelectron Spectroscopy (XPS)
3.6. Scanning Electron Microscopy (SEM)
3.7. Grafting Efficiency
3.8. Mechanical Property Analysis of Fibers
3.9. FTIR Spectroscopy
3.10. Antibacterial Test
4. Conclusions
Author Contributions
Funding
Conflicts of Interest
References
- Altintop, M.D.; Sever, B.; Özdemir, A.; Kuş, G.; Oztopcu-Vatan, P.; Kabadere, S.; Kaplancikli, Z.A. Synthesis and evaluation of naphthalene-based thiosemicarbazone derivatives as new anticancer agents against LNCaP prostate cancer cells. J. Enzym. Inhib. Med. Chem. 2016, 31, 410–416. [Google Scholar] [CrossRef][Green Version]
- West, D.X.; Liberta, A.E.; Padhye, S.B.; Chikate, R.C.; Sonawane, P.B.; Kumbhar, A.S.; Yerande, R.G. Thiosemicarbazone complexes of copper(II): Structural and biological studies. Coord. Chem. Rev. 1993, 123, 49–71. [Google Scholar] [CrossRef]
- Lin, Y.-F.; Hu, Y.-H.; Lin, H.-T.; Liu, X.; Chen, Y.-H.; Zhang, S.; Chen, Q.-X. Inhibitory Effects of Propyl Gallate on Tyrosinase and Its Application in Controlling Pericarp Browning of Harvested Longan Fruits. J. Agric. Food Chem. 2013, 61, 2889–2895. [Google Scholar] [CrossRef] [PubMed]
- Karacan, I.; Erdogan, G. The influence of thermal stabilization stage on the molecular structure of polyacrylonitrile fibers prior to the carbonization stage. Fibers Polym. 2012, 13, 295–302. [Google Scholar] [CrossRef]
- Nam, C.W.; Kim, Y.H.; Ko, S.W. Modification of polyacrylonitrile (PAN) fiber by blending with N-(2-hydroxy)propyl-3-trimethyl-ammonium chitosan chloride. Appl. Polym. 1999, 74, 2113–2332. [Google Scholar] [CrossRef]
- Şahin, K.; Fasanella, N.A.; Chasiotis, I.; Lyons, K.M.; Newcomb, B.A.; Kamath, M.G.; Chae, H.G.; Kumar, S. High strength micron size carbon fibers from polyacrylonitrile–carbon nanotube precursors. Carbon 2014, 77, 442–453. [Google Scholar] [CrossRef]
- Bode-Aluko, C.A.; Pereao, O.; Ndayambaje, G.; Petrik, L. Adsorption of Toxic Metals on Modified Polyacrylonitrile Nanofibres: A Review. Water Air Soil Pollut. 2017, 228–235. [Google Scholar] [CrossRef]
- Wu, G.M.; Shyng, Y.T.; Kung, S.F.; Wu, C.F. Oxygen plasma processing and improved interfacial adhesion in PBO fiber reinforced epoxy composites. Vacuum 2009, 83, 271–274. [Google Scholar] [CrossRef]
- Liu, L.; Huang, Y.D.; Zhang, Z.Q.; Yang, X.B. Effect of ultrasound on wettability between aramid fibers and epoxy resin. Appl. Polym. 2006, 99, 3172–3177. [Google Scholar] [CrossRef]
- Battistel, E.; Morra, M.; Marinetti, M. Enzymatic surface modification of acrylonitrile fibers. Appl. Surf. Sci. 2001, 177, 32–41. [Google Scholar] [CrossRef]
- Kim, Y.-J.; Uyama, H. Tyrosinase inhibitors from natural and synthetic sources: Structure, inhibition mechanism and perspective for the future. Cell. Mol. Life Sci. Cmls 2005, 62, 1707–1723. [Google Scholar] [CrossRef] [PubMed]
- Sánchez-Ferrer, Á.; Neptuno Rodríguez-López, J.; García-Cánovas, F.; García-Carmona, F. Tyrosinase: A comprehensive review of its mechanism. Biochim. Et Biophys. Acta (Bba) Protein Struct. Mol. Enzymol. 1995, 1247, 1–11. [Google Scholar] [CrossRef]
- Chen, L.; Mehta, A.; Berenbaum, M.; Zangerl, A.R.; Engeseth, N.J. Honeys from Different Floral Sources as Inhibitors of Enzymatic Browning in Fruit and Vegetable Homogenates. J. Agric. Food Chem. 2000, 48, 4997–5000. [Google Scholar] [CrossRef] [PubMed]
- Ma, L.; Zhang, M.; Bhandari, B.; Gao, Z. Recent developments in novel shelf life extension technologies of fresh-cut fruits and vegetables. Trends Food Sci. Technol. 2017, 64, 23–38. [Google Scholar] [CrossRef]
- Dong, X.W.; Zhang, Z.; Zhao, J.D.; Lei, J.; Chen, Y.Y.; Li, X.; Chen, H.H.; Tian, J.L.; Zhang, D.; Liu, C.R.; et al. The rational design of specific SOD1 inhibitors via copper coordination and their application in ROS signaling research. Chem. Sci. 2016, 7, 6251–6262. [Google Scholar] [CrossRef]
- Kong, K.H.; Hong, M.P.; Choi, S.S.; Kim, Y.T.; Cho, S.H. Purification and characterization of a highly stable tyrosinase from Thermomicrobium roseum. Biotechnol. Appl. Biochem. 2000, 31, 113–118. [Google Scholar] [CrossRef]
- Mason, H.S. Oxidases. Annu. Rev. Biochem. 1965, 34, 595–634. [Google Scholar] [CrossRef]
- Gans, P.; Sabatini, A.; Vacca, A. Investigation of equilibria in solution. Determination of equilibrium constants with the HYPERQUAD suite of programs. Talanta 1996, 43, 1739–1753. [Google Scholar] [CrossRef]
- Alderighi, L.; Gans, P.; Ienco, A.; Peters, D.; Sabatini, A.; Vacca, A. Hyperquad simulation and speciation (HySS): A utility program for the investigation of equilibria involving soluble and partially soluble species. Coord. Chem. Rev. 1999, 184, 311–318. [Google Scholar] [CrossRef]
- Milunovic, M.N.M.; Enyedy, É.A.; Nagy, N.V.; Kiss, T.; Trondl, R.; Jakupec, M.A.; Keppler, B.K.; Krachler, R.; Novitchi, G.; Arion, V.B. l- and d-Proline Thiosemicarbazone Conjugates: Coordination Behavior in Solution and the Effect of Copper(II) Coordination on Their Antiproliferative Activity. Inorg. Chem. 2012, 51, 9309–9321. [Google Scholar] [CrossRef][Green Version]
- Stokowa-Sołtys, K.; Jeżowska-Bojczuk, M. A rice fungicide blasticidin S efficiently binds Cu(II) ions and prevents DNA from metal-induced damage. J. Inorg. Biochem. 2013, 127, 73–78. [Google Scholar] [CrossRef] [PubMed]
- Niles, A.L.; Moravec, R.A.; Worzella, T.J.; Evans, N.J.; Riss, T.L. High-Throughput Screening Assays for the Assessment of Cytotoxicity. In High-Throughput Screening Methods in Toxicity Testing; Steinberg, P., Ed.; John Wiley & Sons, Inc.: Hoboken, NJ, USA, 2013. [Google Scholar]
- Yokoi, H.; Sai, M.; Isobe, T.; Ohsawa, S. ESR Studies of the Copper (II) Complexes of Ammo Acids. Bull. Chem. Soc. Jpn. 1972, 45, 2189–2195. [Google Scholar] [CrossRef]
- Liu, J.; Wu, F.; Chen, L.; Zhao, L.; Zhao, Z.; Wang, M.; Lei, S. Biological evaluation of coumarin derivatives as mushroom tyrosinase inhibitors. Food Chem. 2012, 135, 2872–2878. [Google Scholar] [CrossRef] [PubMed]
- Matsuura, R.; Ukeda, H.; Sawamura, M. Tyrosinase Inhibitory Activity of Citrus Essential Oils. J. Agric. Food Chem. 2006, 54, 2309–2313. [Google Scholar] [CrossRef] [PubMed]
- Soares, M.A.; Almeida, M.A.; Marins-Goulart, C.; Chaves, O.A.; Echevarria, A.; de Oliveira, M.C.C. Thiosemicarbazones as inhibitors of tyrosinase enzyme. Bioorganic Med. Chem. Lett. 2017, 27, 3546–3550. [Google Scholar] [CrossRef]
- Chang, T.-S. An Updated Review of Tyrosinase Inhibitors. Int. J. Mol. Sci. 2009, 10, 2440–2475. [Google Scholar] [CrossRef]
- Hirose, J.; Iwatzuka, K.; Kidani, Y. Measurement of apparent binding constant between copper ion and apo-bovine superoxide dismutase. Biochem. Biophys. Res. Commun. 1981, 98, 58–65. [Google Scholar] [CrossRef]

| Complex | AtomicMass | Atomic Mass Calculated | Atomic Mass Found | Color | Yield (g) | ||||||
|---|---|---|---|---|---|---|---|---|---|---|---|
| C | H | N | S | C | H | N | S | ||||
| DY1 (C9H11N3OS) | 210.05 | 51.66 | 5.30 | 20.08 | 15.32 | 51.60 | 5.26 | 20.11 | 15.24 | White crystal | 1.39 (66%) |
| DY2 (C8H9N3O2S) | 212.05 | 45.49 | 4.29 | 19.89 | 15.18 | 45.55 | 4.24 | 19.93 | 15.23 | Light yellow | 1.14 (59%) |
| DY3 (C8H8N4O3S) | 241.05 | 40.00 | 3.36 | 23.32 | 13.35 | 39.89 | 3.38 | 23.40 | 13.29 | Yellow solid | 1.41 (63%) |
| DY4 (C9H11N3O2S) | 226.08 | 47.99 | 4.92 | 16.65 | 14.23 | 47.84 | 4.98 | 18.54 | 14.20 | White solid | 1.35 (61%) |
| DY5 (C8H8ClN3OS) | 230.00 | 41.84 | 3.51 | 18.30 | 13.96 | 41.75 | 3.59 | 18.25 | 14.03 | White crystals | 1.60 (71%) |
| DY6 (C12H18N4OS) | 267.15 | 54.11 | 6.81 | 21.03 | 12.04 | 54.14 | 6.79 | 21.10 | 12.09 | Light brown | 1.78 (69%) |
| DY7 (C9H11N3OS) | 238.06 | 51.66 | 5.30 | 20.08 | 15.32 | 51.62 | 5.25 | 20.12 | 15.29 | White solid | 1.32 (69%) |
| Compounds | IC50 (μM) | Concentration of Compounds When 80% of Cells Survive (μM) |
|---|---|---|
| DY1 | 1.88 | <100 μM |
| DY2 | 4.75 | <100 μM |
| DY3 | 9.88 | <50 μM |
| DY4 | 1.12 | <100 μM |
| DY5 | 1.68 | <50 μM |
| DY6 | 0.60 | <100 μM |
| DY7 | 41.2 | <50 μM |
| Ligand | DY1 | DY2 | DY3 | DY4 | DY5 | DY6 |
|---|---|---|---|---|---|---|
| logKCu2+, n = 1, M−1 | 19.15 ± 0.11 | 18.83 ± 0.14 | 19.10 ± 0.15 | 18.95 ± 0.10 | 19.43 ± 0.22 | 20.15 ± 0.14 |
| logKZn2+, n = 1, M−1 | 13.13 ± 0.21 | 13.53 ± 0.11 | 13.69 ± 0.12 | 13.56 ± 0.17 | 12.51 ± 0.20 | 14.07 ± 0.37 |
| logKMn2+, n = 1, M−1 | 13.67 ± 0.31 | 14.27 ± 0.17 | 14.48 ± 0.11 | 14.01 ± 0.08 | 13.65 ± 0.16 | 14.37 ± 0.30 |
| Fibers | Atomic Concentration (%) | Binding Energy/eV | ||||
|---|---|---|---|---|---|---|
| C1S | N1S | O1S | C1S | N1S | O1S | |
| Original PAN fiber | 78.75 | 7.22 | 13.50 | 284.80 | 399.35 | 532.37 |
| DY1–PAN fiber | 73.45 | 14.49 | 11.68 | 284.81 | 399.01 | 530.96 |
| DY2–PAN fiber | 73.22 | 13.78 | 12.74 | 284.80 | 398.20 | 530.86 |
| DY4–PAN fiber | 75.86 | 14.09 | 9.54 | 284.81 | 398.93 | 531.04 |
| DY5–PAN fiber | 74.14 | 16.8 | 8.79 | 284.80 | 398.29 | 530.43 |
| DY6–PAN fiber | 77.70 | 10.96 | 10.96 | 284.80 | 399.44 | 531.64 |
| Grafted (g) | Original (g) | Grafting Efficiency (%) |
|---|---|---|
| 0.4888 | 0.4796 | 1.90 |
| 0.4884 | 0.4798 | 1.89 |
| 0.4889 | 0.4791 | 2.00 |
| 0.4892 | 0.4794 | 2.00 |
| 0.4881 | 0.4793 | 1.80 |
| Mean | 1.92 ± 0.08 | |
| Sample. | Breaking Strength (cN/Tex) | Breaking Elongation (%) |
|---|---|---|
| Original PAN fiber | 21.85 | 43.48 |
| Hydrolyzed PAN fiber | 19.79 | 38.47 |
| DY1 | 20.98 | 41.38 |
| DY2 | 20.78 | 41.29 |
| DY4 | 20.45 | 42.68 |
| DY5 | 20.46 | 40.21 |
| DY6 | 20.34 | 40.60 |
| Bacteria | Thiourea Molecules | Concentration (μM) |
|---|---|---|
| S. aureus | DY1 | 0.02 |
| DY6 | 0.02 | |
| B. subtilis | DY1 | 0.008 |
| DY6 | 0.008 |
© 2019 by the authors. Licensee MDPI, Basel, Switzerland. This article is an open access article distributed under the terms and conditions of the Creative Commons Attribution (CC BY) license (http://creativecommons.org/licenses/by/4.0/).
Share and Cite
Yao, Y.; Liang, Y.; Navik, R.; Dong, X.; Cai, Y.; Zhang, P. Modification of Polyacrylonitrile Fibers by Coupling to Thiosemicarbazones. Materials 2019, 12, 3980. https://doi.org/10.3390/ma12233980
Yao Y, Liang Y, Navik R, Dong X, Cai Y, Zhang P. Modification of Polyacrylonitrile Fibers by Coupling to Thiosemicarbazones. Materials. 2019; 12(23):3980. https://doi.org/10.3390/ma12233980
Chicago/Turabian StyleYao, Yao, Yonghong Liang, Rahul Navik, Xiongwei Dong, Yingjie Cai, and Ping Zhang. 2019. "Modification of Polyacrylonitrile Fibers by Coupling to Thiosemicarbazones" Materials 12, no. 23: 3980. https://doi.org/10.3390/ma12233980
APA StyleYao, Y., Liang, Y., Navik, R., Dong, X., Cai, Y., & Zhang, P. (2019). Modification of Polyacrylonitrile Fibers by Coupling to Thiosemicarbazones. Materials, 12(23), 3980. https://doi.org/10.3390/ma12233980

